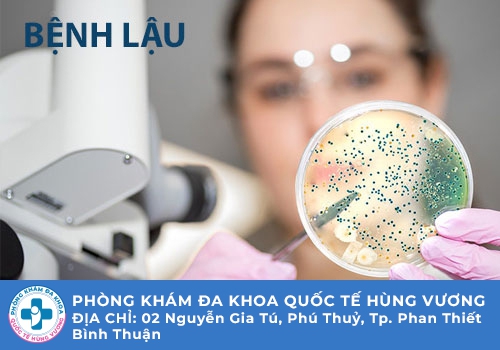

Công ty TNHH MTV dịch vụ y tế Quốc Tế Hùng Vương
02 Nguyễn Gia Tú, Khu phố 14, Thành phố Phan Thiết, Bình Thuận
Liên lạc: 0252.7303.888
Bệnh lậu từ lâu đã được mọi người biết đến là căn bệnh vô cùng nguy hiểm tới sức khỏe. Khi mắc phải căn bệnh này nhiều người lo lắng về biến chứng của bệnh cũng như địa chỉ nào thực hiện xét nghiệm và điều trị uy tín. Ngoài ra bệnh nhân cũng khá quan tâm đến vấn đề với gói xét nghiệm bệnh lậu bao nhiêu tiền? Bài viết dưới đây các chuyên gia tại Phòng Khám Đa Khoa Quốc Tế Hùng Vương sẽ giải đáp thắc mắc đến bạn về vấn đề chi phí nhé.
Bệnh lậu một căn bệnh xã hội có tính truyền nhiễm cao do một loại vi khuẩn có tên Neisseria gonorrhoeae gây ra. Vi khuẩn song cầu lậu khi xâm nhập vào cơ thể của người bệnh sẽ thường hay xuất hiện tại các cơ quan như tử cung, âm đạo, cổ tử cung, ống dẫn trứng, niệu đạo nam giới, hậu môn. Trong một số trường hợp người ta còn có thể phát hiện ra vi khuẩn song cầu lậu tại khoang miệng, vòm họng và mắt.
Con đường lây nhiễm nhanh chóng nhất của bệnh lậu là lây qua đường tình dục. Những người có đời sống tình dục phóng khoáng, quan hệ với nhiều người, quan hệ đồng giới hoặc quan hệ với gái mại dâm là có khả năng bị bệnh cao nhất. Ngoài ra vi khuẩn lậu cũng có thể lây nhiễm thông qua vết thương hở trên da, qua tiếp xúc gián tiếp với các đồ vật, qua đường máu hoặc lây nhiễm từ mẹ sang con.

Vi khuẩn song cầu lậu khi tấn công vào cơ thể sẽ rất nhanh phát triển sau thời gian ủ bệnh là từ 5 - 10 ngày. Nếu để chúng phát triển và không nhanh chóng phát hiện tiêu diệt có thể tấn công sang rất nhiều cơ quan trong cơ thể và gây thương biến chứng nguy hiểm. Nam giới có nguy cơ cao và đối diện với các bệnh lý như viêm niệu đạo, viêm tinh hoàn, viêm tuyến tiền liệt,... còn nữ giới có thể bị viêm buồng trứng, viêm cổ tử cung, viêm ống dẫn trứng,...
Tuy nhiên rất nhiều trường hợp người bệnh đi thăm khám làm xét nghiệm chẩn đoán và điều trị bệnh lậu đều trong tình trạng bệnh đã phát triển nặng. Một phần nguyên do là đến từ việc bệnh nhân lo lắng có xét nghiệm bệnh lậu bao nhiêu tiền, sợ vấn đề chi phí nên không đi thăm khám. Bệnh nhân cần biết rằng bệnh đậu không chỉ ảnh hưởng đến sức khỏe cá nhân mà có thể dẫn tới tình trạng mưu sinh hiếm muộn, ảnh hưởng sức khỏe sinh sản.
Thực chất để khẳng định được mức chi phí cụ thể của gói xét nghiệm bệnh lậu bao nhiêu tiền dường như chưa thể đưa ra được con sâu cụ thể. Vì mức chi phí còn phải phụ thuộc vào rất nhiều yếu tố khác nhau để có thể kết luận. Nếu bệnh nhân thực hiện xét nghiệm tại các cơ sở chuyên khoa uy tín mức chi phí sẽ phụ thuộc vào những yếu tố sau đây:
Trước khi người bệnh thực hiện thăm khám chuyên sâu bất kỳ bệnh gì cũng đều phải khám tổng quát trước tiên. Với mức khám tổng quát này các bác sĩ sẽ tìm hiểu xem bạn có dấu hiệu của bệnh lậu hay không, nắm bắt sơ bộ về đời sống tình dục cũng như khả năng nguồn lây của bạn. Và bước khám tổng quát này cũng sẽ nằm trong mức tiền chi phí Bạn phải chi trả khi tham gia xét nghiệm bệnh lậu.
Một yếu tố quan trọng ảnh đến chi phí của gói xét nghiệm là bạn sẽ thực hiện theo phương pháp nào. Hiện nay có rất nhiều các phương pháp để bệnh nhân thực hiện xét nghiệm chẩn đoán bệnh lậu. Bệnh nhân có thể lựa chọn theo chỉ định của bác sĩ cũng như phù hợp với điều kiện kinh tế. Và mỗi phương pháp xét nghiệm sẽ có mức chi phí khác nhau nên tổng tiền của gói xét nghiệm của mỗi người cũng sẽ không giống nhau.
Thông thường chi phí xét nghiệm theo các phương pháp truyền thống sẽ tiết kiệm hơn so với các phương pháp hiện đại. Thông thường chi phí xét nghiệm theo các phương pháp truyền thống sẽ tiết kiệm hơn so với các phương pháp hiện đại Tuy nhiên thực hiện xét nghiệm chẩn đoán theo phương pháp hiện đại kết quả sẽ chính xác cao hơn và thời gian sẽ nhanh chóng hơn.
Có nhiều bệnh nhân lo lắng về vấn đề chi phí nên để tiết kiệm để chọn đến những cơ sở không rõ nguồn gốc, không đảm bảo chất lượng để xét nghiệm. Đây là việc rất nguy hiểm vì có thể tình trạng bệnh không được chẩn đoán đúng, ảnh hưởng đến việc điều trị, khiến bệnh càng trở nên nghiêm trọng hơn.
Bạn nên lựa chọn những cơ sở chuyên khoa y tế uy tín an toàn để tránh những rủi ro không đáng có. Chi phí chữa trị tại các cơ sở uy tín có thể cao hơn tuy nhiên tại đây có đầy đủ các thiết bị máy móc hiện đại và bác sĩ có trình độ chuyên môn để thực hiện các xét nghiệm cần thiết cho bạn.
Bệnh lậu là căn bệnh vô cùng nguy hiểm nên không nên vì vấn đề chi phí mà chủ quan chọn cơ sở kém chất lượng. Và thực chất Nếu lựa chọn cơ sở uy tín bạn cũng không cần lo lắng về chi phí vì những cơ sở này sẽ đưa ra mức chi phí hợp lý và công khai một cách cụ thể.
Nếu bạn đang lo lắng về gói xét nghiệm bệnh lậu bao nhiêu tiền và muốn tìm kiếm một cơ sở có mức chi phí phù hợp nhưng vẫn đảm bảo chất lượng thì đừng bỏ qua Phòng Khám Đa Khoa Quốc Tế Hùng Vương có địa chỉ nằm tại 02 Nguyễn Gia Tú, Khu phố 14, Thành phố Phan Thiết, Bình Thuận. Bệnh nhân khi đến đây thực hiện xét nghiệm tiến hành điều trị cũng có thể yên tâm vì những yếu tố chất lượng mà cơ sở mang đến như sau:
► Phòng khám có nhiều bác sĩ vừa giỏi chuyên môn, vừa có tay nghề y học cao, luôn đồng hành và ủng hộ bệnh nhân vượt qua chướng ngại tâm lý để yên tâm điều trị bệnh.
► Nhân viên y tế của phòng khám cũng làm việc và giúp đỡ bệnh nhân một cách nhiệt tình, đặc biệt sẽ hướng dẫn chi tiết trong các thủ tục hành chính để bệnh nhân cảm thấy dễ dàng hơn.

► Các phương pháp xét nghiệm tại phòng khám rất hiện đại. với việc áp dụng hệ thống thiết bị máy móc tiên tiến, được phòng khám nhập khẩu từ các nước phát triển.
► Phòng khám đưa ra mức chi phí phù hợp, có hóa đơn rõ ràng, trước khi điều trị bác sĩ sẽ gặp riêng bệnh nhân để tư vấn cụ thể.
Những chia sẻ trên đây của chúng tôi chắc hẳn bạn đã giải đáp được thắc mắc gói xét nghiệm bệnh lậu bao nhiêu tiền? Nếu còn bất kỳ thắc mắc nào liên quan đến bệnh xã hội muốn hỗ trợ thêm bạn có thể gọi điện đến hotline 0252.7303.888 của Phòng Khám Đa Khoa Quốc Tế Hùng Vương là hay Click vào khung chat ngay dưới đây để tư vấn viên trực tổng đài 24/7 hỗ trợ bạn kịp thời.
Phòng Khám Đa Khoa Quốc Tế Hùng Vương địa chỉ: 02 Nguyễn Gia Tú, Khu phố 14, Thành phố Phan Thiết, Bình Thuận
- Đặt lịch hẹn qua số điện thoại: 0252.7303.888 để được đăng ký khám sớm không mất công chờ đợi.
- Đăng ký ngay để nhận tư vấn và dịch vụ ưu đãi: